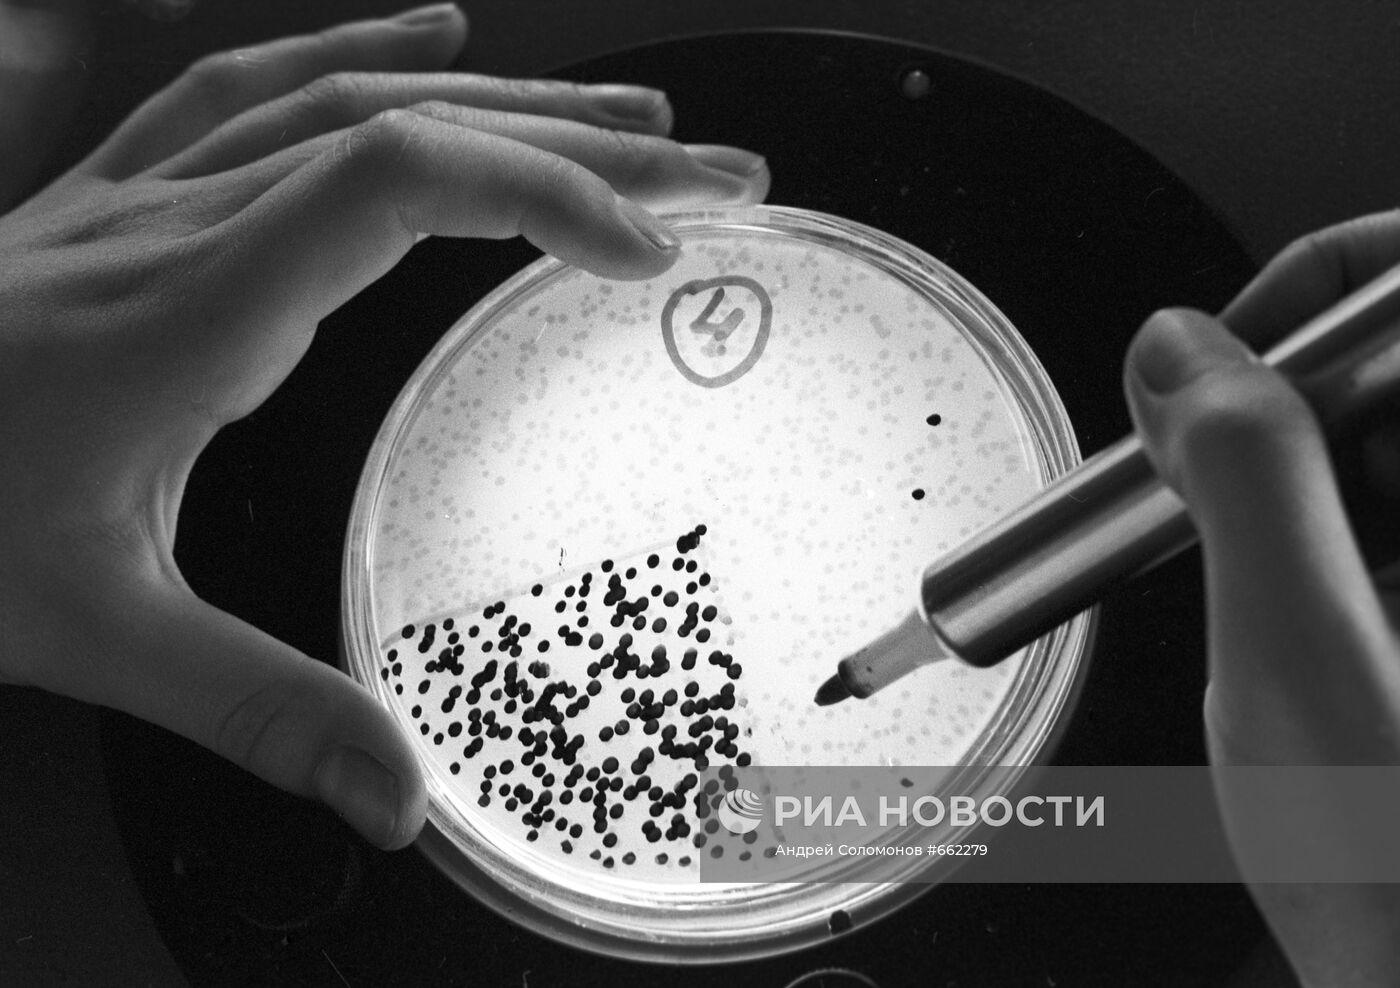
Институт молекулярной биологии Академии наук СССР

Анализ бактериофагов в лаборатории Института молекулярной биологии Академии наук СССР (Институт молекулярной биологии имени В. А. Энгельгардта Российской академии наук).
- Категории: Трудовые отношения. Занятость, Наука и технологии
- Место: Москва, Россия
- Дата события: 01.06.1980
- Дата поступления: 12.05.2010
- Автор: Андрей Соломонов
- Кредит: РИА Новости
- Источник: РИА Новости
- Оригинал: 80-9807, 35 мм негатив
- Формат: JPEG, 5020x3543px, 2.3Mb